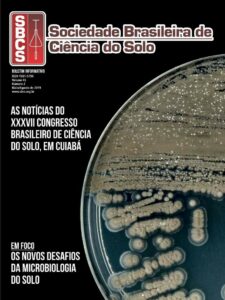

Boletins (PDF)
Publicação editada pela Secretaria Executiva da SBCS. Tem por objetivos esclarecer as principais atividades da Sociedade e difundir notícias de interesse dos associados. Os conceitos emitidos em artigos assinados são de exclusiva responsabilidade de seus autores, não refletindo, necessariamente, a opnião da SBCS.
Permite-se a reprodução, total ou parcial, dos artigos e reportagens, desde que seja explicitamente indicada a sua origem.
Disponível para download no site da SBCS.
Boletim Informativo SBCS
Editor-chefe: Raphael B. A. Fernandes (UFV)
Co-editor: Reinaldo Bertola Cantarutti
Produção, jornalismo e edição: Léa Medeiros MTB 5084
Fotos do 21st WCSS: Valéria Vieira Fotografia
Diagramação: Carlos Joaquim Einloft
Volume 45, Número 2

Volume 45, Número 1

Volume 44, Número 3

Volume 44, Número 2

Volume 44, Número 1

Volume 43, Número 3

Volume 43, Número 2

Volume 43, Número 1

Volume 42, Número 3

Volume 42, Número 2




